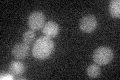
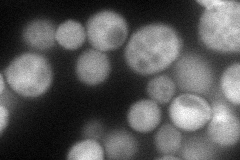
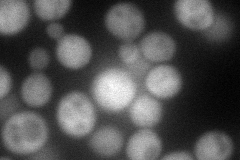
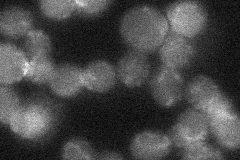

View description
Mu2-like subunit of the clathrin associated protein complex (AP-2); involved in vesicle transport
Localization:
Intensity:
Fold change:
Significance:
-
C’ GFP library in SD
below threshold15.52 -
N' NOP1pr-GFP in SD
cytosol83.9117 -
N' TEF2pr-mCherry in SD
cytosol86.5227 -
N' NATIVEpr-GFP in SD
punctate,bud neck23.1141 -
N' TEF2pr-VC and Cyto-VN in SD

cytosol45.3697 -
C’ GFP library in SD+DTT

cytosol17.071.09No -
C’ GFP library in SD+H2O2

cytosol150.96No -
C’ GFP library in Starvation Media

cytosol18.41.18No -
C’ GFP library on the background of Pup2-DaMP

below threshold -
C’ GFP library on the background of CCT mutant

below threshold15.86171.02143No
